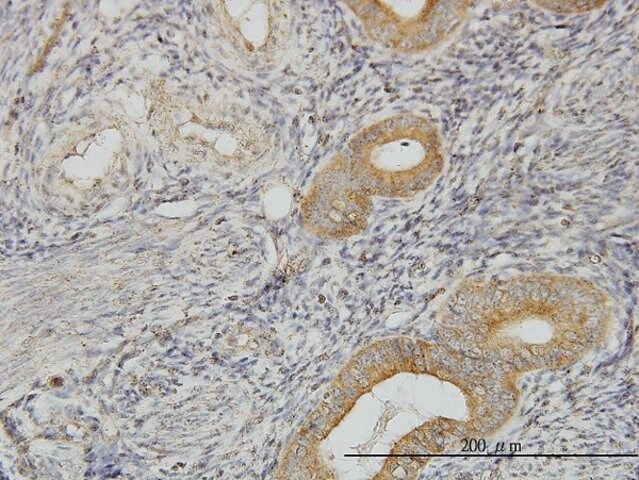

ن؛§ه“پهگچ称9ü/div>
Monoclonal Anti-F8 antibody produced in mouse
FVIII
F8B
AHF
F8C
HEMA
ن؛§ه“پن»‹ç»چï¼™ü/div>
ن؛§ه“پ说وکژ
ه…چç–«هژü/p>
Purified recombinant fragment of F8 expressed inE.coli.
Mouse monoclonal antibody raised against F8
ه¤–ه½¢
Ascitic fluid containing 0.03% sodium azide.
ه…چè´£ه£°وکژ
Unless otherwise stated in our catalog or other company documentation accompanying the product(s), our products are intended for research use only and are not to be used for any other purpose, which includes but is not limited to, unauthorized commercial uses, in vitro diagnostic uses, ex vivo or in vivo therapeutic uses or any type of consumption or application to humans or animals.
هں؛وœ¬ن؟،وپ¯
ن؛§ه“پو€§è´¨
| è´¨é‡ڈو°´ه¹³ |
100 |
| ç”ں物و¥و؛گ |
mouse |
| هپ¶èپ”ç‰?/td> |
unconjugated |
| وٹ—ن½“ه½¢ه¼ڈ |
ascites fluid |
| antibody product type |
primary antibodies |
| ه…‹éڑ† |
5E9B2, monoclonal |
| species reactivity |
human |
| technique(s) |
direct ELISA: 1:10,000
western blot: 1:500-1:2,000 |
| هگŒن½چç´?ن؛ڑه‹ |
IgG1 |
| UniProt登记هڈ¶ü/td> |
P00451 |
| è؟گ输 |
wet ice |
| ه‚¨هکو¸©ه؛¦ |
?20â„‚ü/td> |
| Gene Information |
human ... F8(2157) |
ه®‰ه…¨ن؟،وپ¯
| ه‚¨هکهˆ†ç±»ن»£ç پ |
12 - Non Combustible Liquids |
| WGK |
WGK 3 |
| é—ھ点(F) |
Not applicable |
| é—ھ点(C) |
Not applicable |
 m.cnreagent.com
m.cnreagent.com